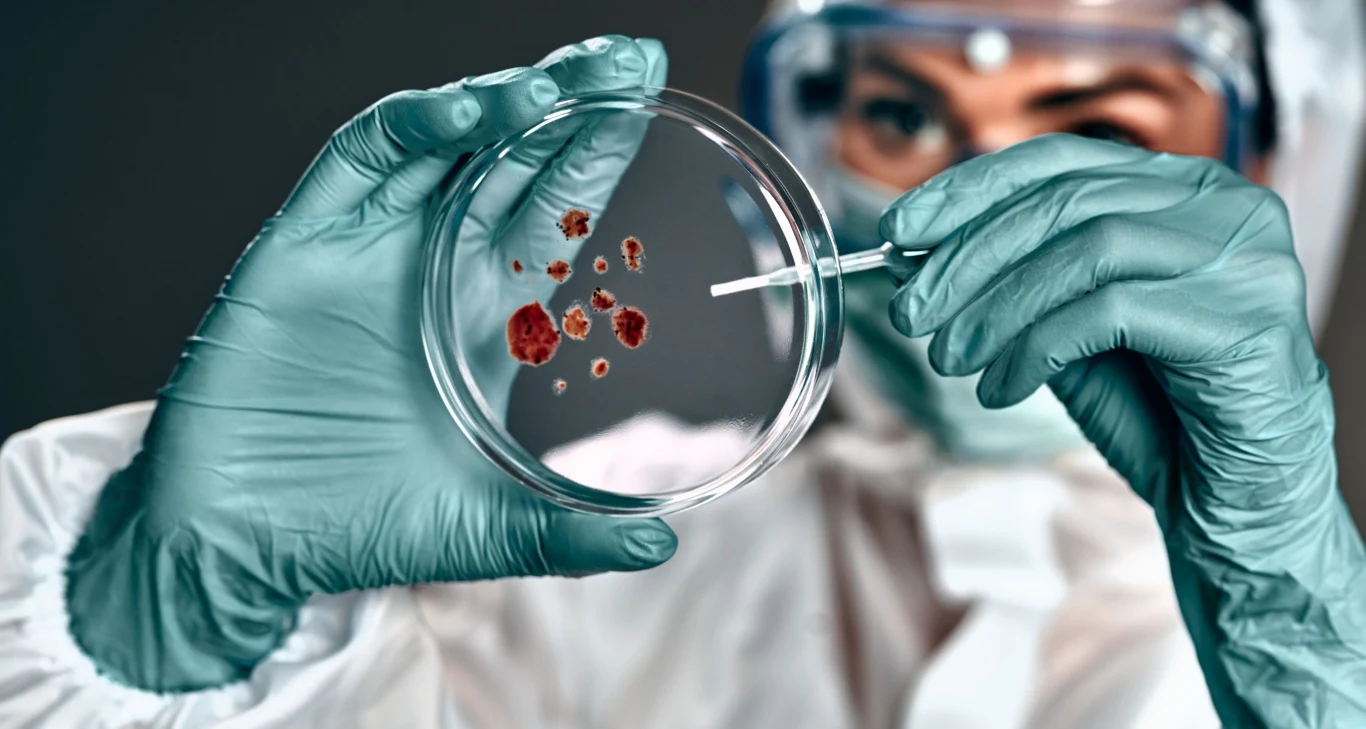
Bakterie, wirusy i inne patogeny przestają reagować na dostępne leki Nowa forma oporności na antybiotyki. Bakterie kradną nasze substancje odżywcze

To cicha pandemia. Zabija więcej dzieci niż nowotwory
Jak wynika z najnowszego raportu przygotowanego przez dwóch światowych ekspertów, dr Yanhong Jessikę Hu z Murdoch Children's Research Institute i prof. Herba Harwella z Clinton Health Access Initiative, ponad 3 miliony dzieci na całym świecie zmarło w 2022 roku z powodu infekcji, na które nie działały dostępne antybiotyki.
Oporność na środki przeciwdrobnoustrojowe (AMR) rozwija się, gdy drobnoustroje wywołujące infekcje ewoluują w taki sposób, że leki przestają działać - została ona uznana za jedno z najpoważniejszych zagrożeń dla zdrowia publicznego na świecie. Mówiąc krótko, bakterie, wirusy i inne patogeny przestają reagować na dostępne leki, co prowadzi do infekcji niemożliwych do wyleczenia.
W ciągu trzech lat liczba takich infekcji wzrosła ponad dziesięciokrotnie, głównie z powodu masowego i niekontrolowanego użycia antybiotyków w czasie pandemii. Najwięcej zgonów odnotowano w Afryce i Azji Południowo-Wschodniej, gdzie dostęp do czystej wody i podstawowej opieki zdrowotnej jest ograniczony.
Nadużywamy antybiotyków ostatniej szansy
Jednocześnie między 2019 a 2021 rokiem stosowanie antybiotyków "z grupy ostrzeżenia" wzrosło aż o 160 proc. w Azji Południowo-Wschodniej i o 126 proc. w Afryce, a jeszcze bardziej alarmujące są dane dotyczące antybiotyków "ostatniej szansy", stosowanych w sytuacjach, kiedy nic innego nie działa - były tam stosowane odpowiednio o 45 i 125 proc. częściej.
Jeśli bakterie uodpornią się na ostatnie linie obrony, zabraknie nam skutecznych opcji leczenia
Eksperci są zgodni, najskuteczniejszą bronią przeciwko narastającej lekooporności jest prewencja. Potrzebne są szeroko zakrojone działania, jak poprawa higieny, dostępu do czystej wody oraz zwiększenie liczby szczepień ochronnych, zwłaszcza w krajach rozwijających się. Ich zdaniem już teraz potrzebujemy globalnego planu działania - nie możemy czekać, aż sytuacja wymknie się spod kontroli.
Niespodziewany sojusznik
Przy okazji dowiadujemy się też o innych badaniach, które sugerują, że mogliśmy zyskać nowego sojusznika w walce z lekoopornymi bakteriami. Dowiadujemy się z nich, że już niewielka ilość popularnego sztucznego słodzika - sacharyny - może zakłócać zdolność bakterii do tworzenia biofilmu, czyli ochronnej warstwy, która czyni je trudnymi do zwalczenia. W eksperymentach laboratoryjnych dodanie sacharyny do środowiska bakterii Pseudomonas aeruginosa, czyli groźnego patogenu szpitalnego, znacząco osłabiło jego oporność na antybiotyki.
Co ważne, działanie słodzika nie polegało na bezpośrednim zabijaniu drobnoustrojów, lecz na osłabieniu ich mechanizmów obronnych, co zwiększyło skuteczność terapii antybiotykowej. Odkrycie to otwiera nową ścieżkę w projektowaniu terapii wspomagających leczenie infekcji bakteryjnych, szczególnie w czasach narastającej antybiotykooporności.











